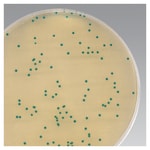
Chromogenic Cronobacter Isolation Agar (Dehydrated)

Search
Thermo Scientific™
发色克罗诺杆菌分离琼脂(干粉)
采用本款发色培养基对婴儿配方奶粉和其他食品样品中的阪崎克罗诺杆菌进行鉴别和计数。
| 货号 | 数量 |
|---|---|
| CM1122B | 500 g |
货号 CM1122B
价格(CNY)
-
数量:
500 g
采用 Thermo Scientific Oxoid 发色克罗诺杆菌分离琼脂(干粉)对婴儿配方奶粉和其他食品样品中的™阪崎克罗诺杆菌™进行鉴别和计数。发色克罗诺杆菌分离琼脂 (CCI) 是 Brilliance™阪崎克罗诺杆菌琼脂 (DFI) 的增强配方,采用改进的特异性和菌落色彩用于检测克罗诺杆菌。
阪崎克罗诺杆菌是一种革兰氏阴性杆菌,极少引起健康成人患病。它与早产儿(新生儿)的疾病暴发有关。研究指出,新生儿或有其他疾病的婴儿更易发生此感染。报告的大多数感染病例为重症,包括脓毒症(血液中的细菌)、脑膜炎或坏死性小肠结肠炎(严重的肠道感染)。
使用发色克罗诺杆菌分离琼脂对婴儿配方奶粉和其他食品样品中的阪崎克罗诺杆菌进行鉴别和计数。
- 选择性:由于有去氧胆酸盐,本款培养基对大多数革兰氏阳性菌具有选择性。
- 易于读取:阪崎克罗诺杆菌在这种培养基中形成蓝绿色菌落。
已从婴儿配方奶粉中分离出低水平的克罗诺杆菌属,该生物体对干燥具有高耐受性,在奶粉工厂的干燥环境中具有竞争优势,增加了产品污染的风险1。
发色克罗诺杆菌分离 (CCI) 琼脂是原版 Brilliance™ 阪崎肠杆菌琼脂 (DFI) 的优化版,原版由 Iversen 等人在 2004 年开发3。增加了 X-α-葡萄糖苷发色剂的浓度,以提高葡萄糖苷酶活性较弱的克罗诺杆菌菌株的蓝绿着色。加入硫代硫酸钠和柠檬酸铁铵 (III),以区分会生成硫化氢的肠杆菌科,其颜色为灰/棕色,添加去氧胆酸钠抑制革兰氏阳性竞争菌的生长。
并非所有产品在所有国家(地区)均有售。请咨询相关销售人员。
Remel™ 和 Oxoid™ 产品现已归属 Thermo Scientific 品牌旗下。
仅限实验室使用
1.Lai.2001.Medicine.80.113-122
规格
描述发色克罗诺杆菌分离琼脂
数量500 g
产量适用于 16.3 L 培养基
形式粉末
产品类型Media Broth
种属Cronobacter
Unit SizeEach